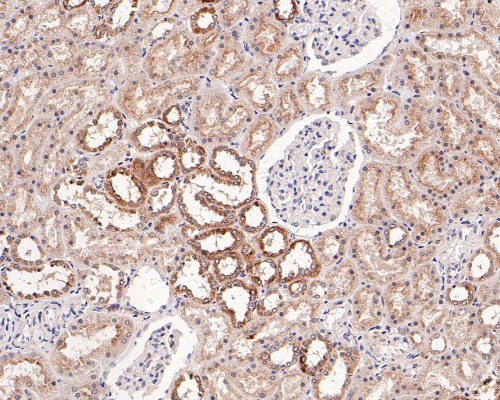
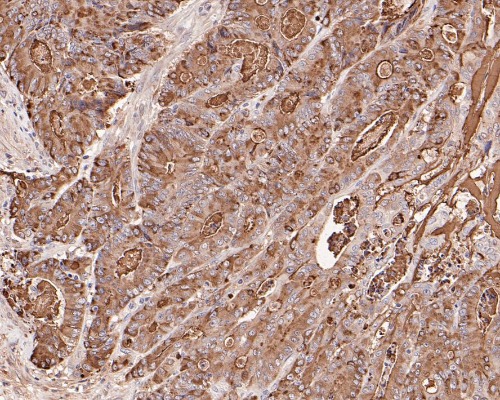

TSG101 Rabbit Monoclonal Antibody
|
Application |
Dilution Ratio |
|
IHC-P |
1:500 - 1:1000 |
|
Antibody Type |
Recombinant Rabbit monoclonal Antibody |
|
Immunogen |
Synthetic peptide within Human TSG101 aa 24-73 / 390. |
|
Species Reactivity |
Human, Mouse, Rat |
|
Validated Applications |
WB, IF-Cell, IF-Tissue, IHC-P, FC |
|
Molecular Weight |
Predicted band size: 44 kDa |
|
Positive Control |
HeLa cell lysate, K-562 cell lysate, MCF7 cell lysate, Jurkat cell lysate, C2C12 cell lysate, PC-12 cell lysate, mouse brain tissue lysate, rat brain tissue lysate, HeLa, NIH/3T3, PC-12, human kidney tissue, mouse colon tissue, mouse kidney tissue, human colon carcinoma tissue. |
|
Conjugation |
unconjugated |
|
RRID |
AB_3068599 |
|
Form |
Liquid |
|
Storage Buffer |
1*TBS (pH7.4), 0.05% BSA, 40% Glycerol. Preservative: 0.05% Sodium Azide |
|
Isotype |
IgG |
|
Purification Method |
Protein A affinity purified |
Immunohistochemical staining of human kidney tissue was performed using TSG101 Rabbit Monoclonal Antibody(ARA962).
Immunohistochemical staining of human colon carcinoma tissue sections was performed using TSG101 Rabbit Monoclonal Antibody(ARA962).
New Products
